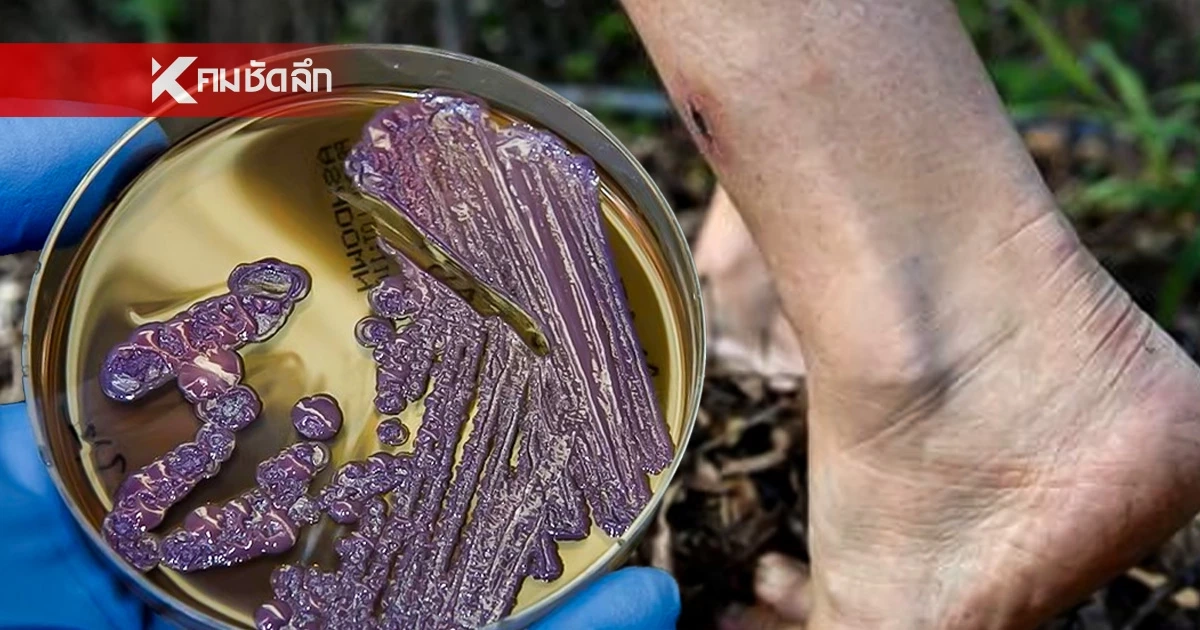
รู้จัก "โรคไข้ดิน" ภัยเงียบคร่าชีวิต  "มหิดล" แนะนวัตกรรมใหม่ตรวจเจอใน 15 นาที

รู้จัก "โรคไข้ดิน" ภัยเงียบคร่าชีวิต "มหิดล" แนะนวัตกรรมใหม่ตรวจเจอใน 15 นาที
อย่าชะล่าใจ "ไข้ดิน" ไม่ใช่แค่ไข้หวัด เปิดพฤติกรรมเสี่ยงทำชีวิตพัง วิธีสังเกตอาการ รู้เร็ว-รอดเร็ว "มหิดล" แนะนวัตกรรมใหม่ตรวจเจอใน 15 นาที!
สธ. ยกระดับเฝ้าระวัง "โรคไข้ดิน" (Melioidosis) หลังพบยอดผู้ป่วยพุ่งสูงและเสียชีวิตต่อเนื่อง เหตุวินิจฉัยล่าช้าจนเชื้อเข้ากระแสเลือด โรคไข้ดิน หรือ โรคเมลิออยโดสิส สามารถรักษาให้หายขาดได้ หากมีการวินิจฉัยถูกต้องตั้งแต่ระยะแรก รักษาโดยการให้ยาปฏิชีวนะใน 2 สัปดาห์แรกด้วยวิธีฉีด หลังจากนั้นแพทย์จะให้ยาชนิดกินต่อไปเป็นเวลา 5 เดือน หากมีภาวะแทรกซ้อนอาจให้ยาเพิ่มขึ้นตามความเหมาะสม ล่าสุด มหาวิทยาลัยมหิดลโชว์นวัตกรรมชุดตรวจคัดกรองเร็ว แม่นยำสูง รู้ผลใน 15 นาที กระจายสู่ รพ. ทั่วประเทศ หวัง "รู้เร็ว-รอดเร็ว" ก่อนช็อกดับ!
สถานการณ์ปัจจุบัน "โรคไข้ดิน" กลายเป็นความท้าทายครั้งใหญ่ของสาธารณสุขไทย เชื้อแบคทีเรีย Burkholderia pseudomallei ที่แฝงตัวอยู่ในดินและน้ำตามนาข้าวและพื้นที่เกษตรกรรม กำลังจู่โจมผู้ที่มีบาดแผลหรือภูมิคุ้มกันต่ำ โดยเฉพาะกลุ่มเกษตรกรที่มักละเลยการสวมใส่รองเท้าบูท ทำให้เชื้อเข้าสู่ร่างกายได้โดยง่าย
อาการอันตราย: อย่าชะล่าใจแค่คิดว่าเป็น "ไข้หวัด"
ความน่ากลัวของโรคนี้คืออาการเบื้องต้นที่คล้ายไข้ทั่วไป ทำให้ผู้ป่วยมาพบแพทย์ช้า จนเชื้อลุกลามไปยังอวัยวะสำคัญ
- ติดเชื้อที่ผิวหนัง: เกิดแผลเรื้อรัง ฝี หนอง หรือต่อมน้ำเหลืองโต
- ติดเชื้อในปอด: ไข้สูง ไอ มีเสมหะ (มักถูกวินิจฉัยสับสนกับวัณโรค)
- ติดเชื้อในกระแสเลือด (อันตรายที่สุด): ความดันต่ำ ช็อก เป็นฝีในตับและม้าม สามารถเสียชีวิตได้ภายใน 2-3 วัน หากรักษาไม่ถูกต้อง
ทางด้าน ศ.ดร.นริศรา จันทราทิตย์ ภาควิชาจุลชีววิทยาและอิมมิวโนโลยี คณะเวชศาสตร์เขตร้อน มหาวิทยาลัยมหิดล ระบุว่า หนึ่งในความท้าทายสำคัญของการรักษา คือข้อจำกัดด้านเวลา เนื่องจาก ผู้ป่วยโรคไข้ดินในระยะวิกฤตอาจเสียชีวิตภายใน 48 ชั่วโมงแรก ขณะที่การตรวจวินิจฉัยด้วยวิธีมาตรฐานอย่างการเพาะเชื้อใช้เวลานานถึง 3–7 วัน ส่งผลให้ผู้ป่วยจำนวนมากไม่สามารถเข้าถึงการรักษาที่เหมาะสมได้ทันเวลา “หลายเคส ‘รอผลไม่ได้’ นี่คือช่องว่างสำคัญที่ทำนำไปสู่การสูญเสีย”
เพื่อตอบโจทย์ปัญหานี้ ศ.ดร.นริศรา จันทราทิตย์ และทีมวิจัย มหาวิทยาลัยมหิดลได้พัฒนานวัตกรรม MUTM Melioidosis Antibody Test ชุดตรวจโรคไข้ดินแบบรวดเร็ว (Rapid Test) ที่สามารถให้ผลเบื้องต้นได้ภายใน 10–15 นาทีด้วยความแม่นยำมากกว่า 95% นวัตกรรมนี้ช่วยให้แพทย์สามารถ วินิจฉัยโรคได้ตั้งแต่ระยะแรก ให้ยาปฏิชีวนะที่จำเพาะได้ทันที และลดความเสี่ยงการเสียชีวิตอย่างมีนัยสำคัญ
ปัจจุบัน นวัตกรรมชุดตรวจโรคไข้ดินแบบรวดเร็ว MUTM Melioidosis Antibody Test ได้รับการพัฒนาเสร็จสมบูรณ์ในระดับ พร้อมใช้งานทางการแพทย์ และ เปิดให้โรงพยาบาลรัฐ เอกชน คลินิก และหน่วยบริการสุขภาพทั่วประเทศ สามารถสั่งซื้อและนำไปใช้ได้ทันที โดยดำเนินการผลิตและกระจายผ่านความร่วมมือระหว่างมหาวิทยาลัยมหิดล และภาคเอกชน บริษัท Sierra
เพื่อรองรับความต้องการใช้งานในวงกว้างอย่างรวดเร็ว



